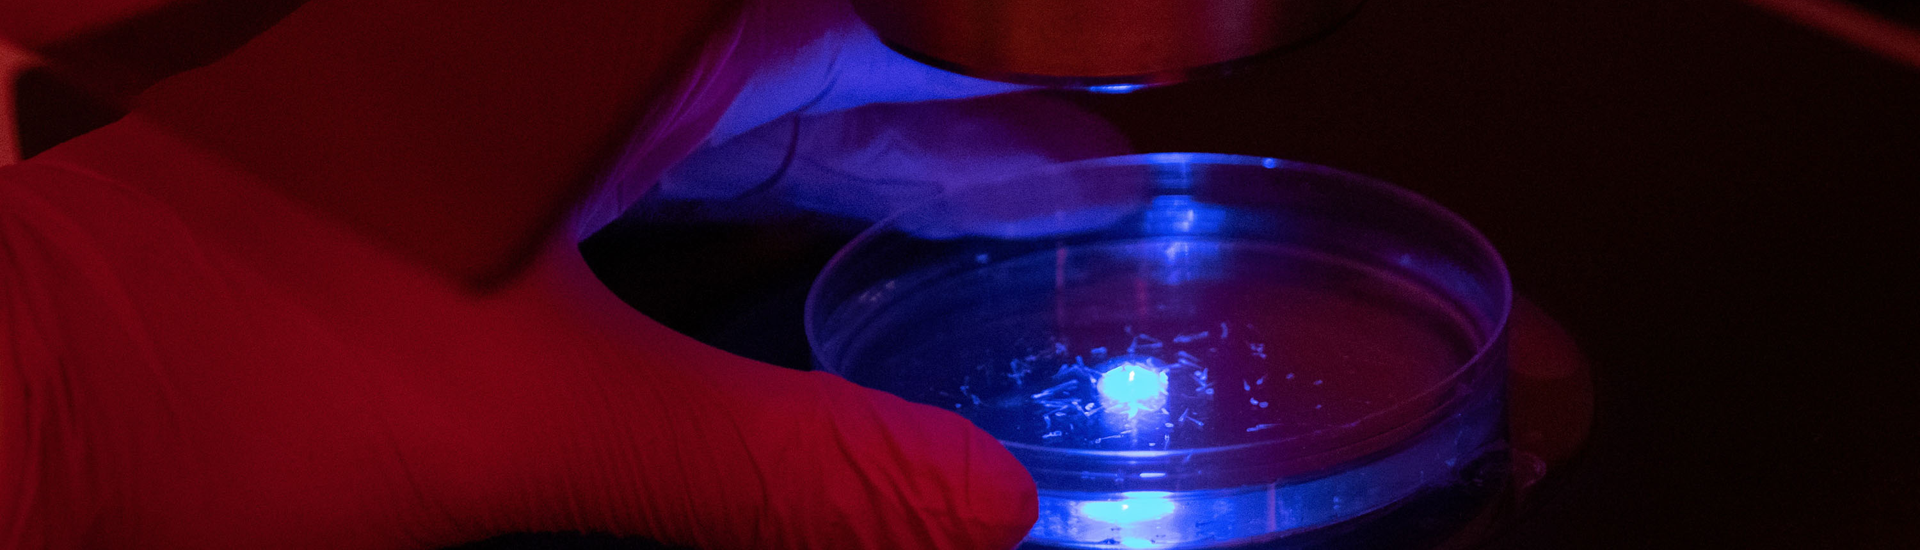
Petri dish under microscope lit in blue light

Specialized facility illuminates genetic mechanisms underlying human health conditions
Summary:
Modelling health conditions in zebrafish is paving the way for genetic discoveries that may change the course of care for children around the world.
When a clinician or scientist suspects that a particular gene is contributing to a child’s condition, whether it’s a rare condition like nemaline myopathy or very early onset inflammatory bowel disease, their next step is to verify that suspicion – that’s where zebrafish come in.
In the largest facility of its kind in Canada, the Zebrafish Genetics and Disease Models Core at The Hospital for Sick Children (SickKids) helps provide insight into the molecular genetic mechanisms underlying health conditions which can point towards potential treatment strategies for people living with those conditions.
“Our facility can rapidly and affordably determine whether genetic variations may be influencing specific human health conditions,” says Dr. Jason Burgess, Facility Manager. “Laying the groundwork for future research and supporting the discovery of new therapeutics that hopefully result in real world interventions.”
The genetic power of zebrafish
Advances in high-throughput DNA sequencing have led to the discovery of many human conditions associated with genetic variants of unknown significance. However, it can be difficult to determine if a genetic variant is inconsequential, or directly responsible for the observed health condition.

Seventy per cent of human genes have an obvious zebrafish ortholog. Orthologous genes share the same ancestor gene, even though they have evolved to be present in different species. For human genes that are involved in health conditions, the number of human-zebrafish orthologs rises to over 80 per cent. Thanks to these genetic similarities, scientists can develop insights in zebrafish that can be readily applied to humans.
Among the many strengths of zebrafish models, research teams can inactivate a single one of these genes and observe its effect on zebrafish development and behavior, providing evidence to support the team’s future research. This evidence is an important step towards other preclinical, and clinical trials, and makes the facility a cornerstone of SickKids’ vision for Precision Child Health, a movement to deliver individualized care for every patient.
“Much of the research underlying Precision Child Health depends on reliable pre-clinical models,” says Scientific Co-Director Dr. Jim Dowling, Staff Clinician and Senior Scientist in the Genetics & Genome Biology program. “The technology and expertise in this core facility makes us well-positioned to study and validate new clinical genetic discoveries, and to identify and develop novel potential therapeutics that could transform care for children at SickKids and around the world.”
Lighting up research

In addition to the genetic similarities, zebrafish also produce a large number of embryos to support high-throughput screening. These embryos are also transparent, allowing scientists to visually examine the changes that occur during embryo development.
This examination is strengthened by resources at the SickKids Imaging Facility, a close collaborator of the facility, which enables scientists to take fluorescent images and see details at the cellular level.
“Using the power of genetic and live imaging technologies, we can visually observe mechanisms involved in the formation of complex organ systems like the brain and spine, informing new approaches to paediatric care,” says Scientific Co-Director Dr. Brian Ciruna, Senior Scientist and Head of the Developmental & Stem Cell Biology program.
Today, the Zebrafish Genetics and Disease Models Core is continuing to add to its vast repository of zebrafish lines and implement new techniques that keep up with quickly advancing genetic technologies. The facility supports more than 22 labs at SickKids alone, and recent publications they supported include the genetics of congenital muscular dystrophy (Human Molecular Genetics, 2022) and whole genome sequencing in early onset cardiomyopathy (NPJ Genomic Medicine, 2022).
Looking to advance your research?
The SickKids Zebrafish Genetics and Disease Models Core is open to researchers at SickKids and in the external scientific community.
